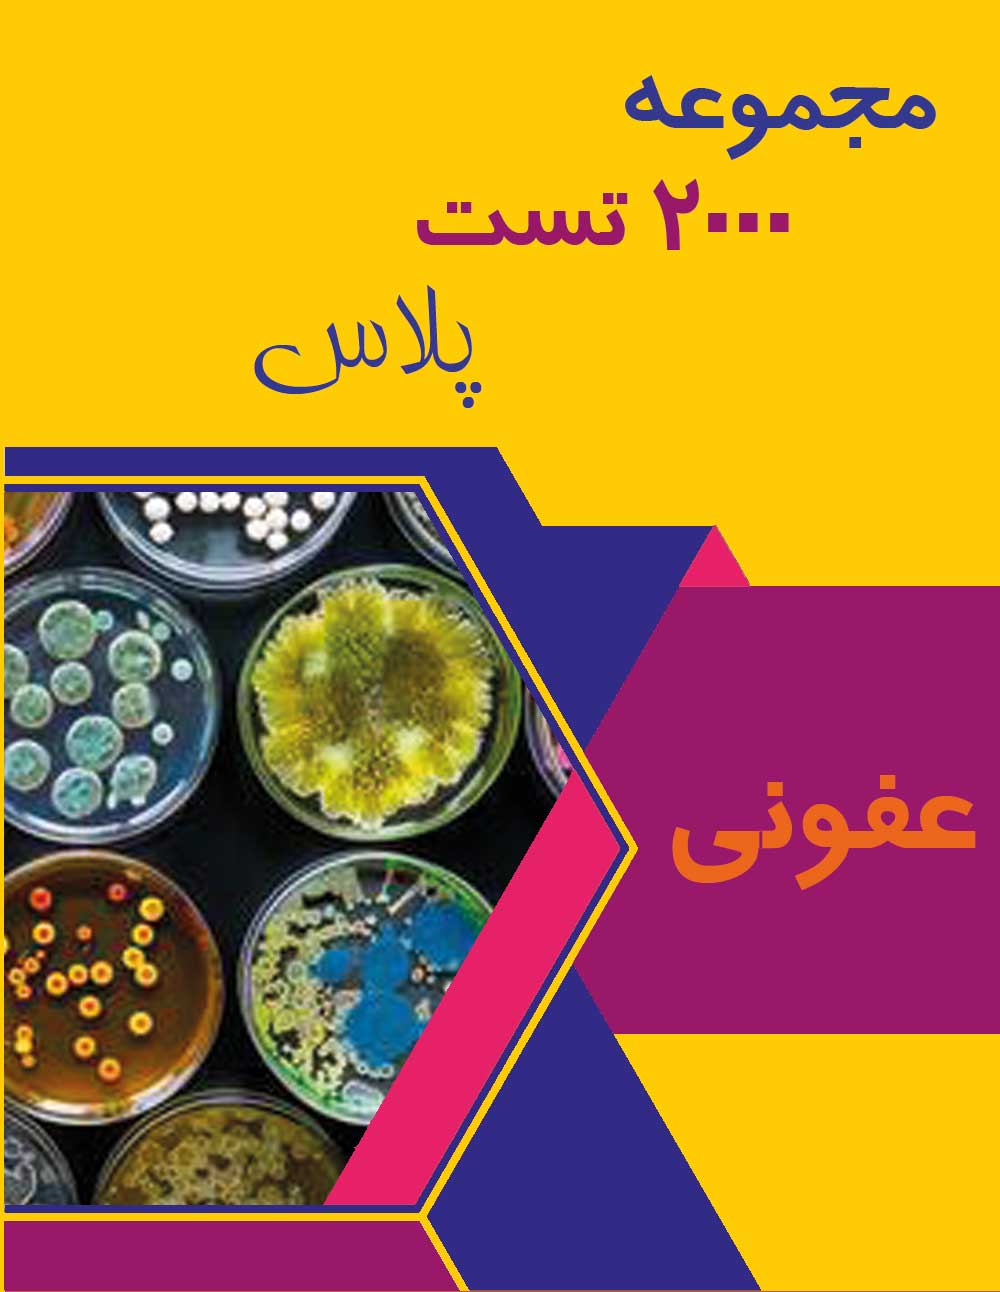
عفونی 2000 تست پلاس

توضیحات
📘 ۲۰۰۰ تست پلاس – مبحث عفونی
ویژه آمادگی آزمونهای پیشکارورزی و دستیاری پزشکی
مبحث عفونی در نسخهی جدید ۲۰۰۰ تست پلاس با رویکردی دقیق، علمی و کاملاً بهروزرسانی شده توسط دکتر مهدی ایزدی تدوین گردیده است. این مجموعه با تحلیل سؤالات سالهای گذشته و بازنویسی پاسخها براساس جدیدترین رفرنسهای عفونی، یک ابزار قدرتمند برای داوطلبانی است که میخواهند در مباحث مربوط به بیماریهای عفونی، میکروبی و ویروسی بیشترین تسلط را کسب کنند.
در این بسته، سؤالات آزمونها بهصورت تشریحی، تحلیلی و نکتهمحور ارائه شدهاند تا علاوه بر یادگیری پاسخ صحیح، ذهن داوطلب با منطق حل سؤال و نکات کلیدی هر موضوع آشنا شود. ساختار محتوا بهگونهای طراحی شده که مطالعهٔ مرحلهبهمرحله و جمعبندی سریع را بسیار آسان میکند.
✳️ ویژگیهای این مبحث:
-
پوشش جامع سؤالات پرتکرار و مهم بیماریهای عفونی، باکتریولوژی، ویروسها و پروتوزوآ
-
پاسخهای مستند و تحلیلی بر اساس آخرین ویرایش رفرنسهای معتبر
-
ارائه نکات کلیدی بالینی برای افزایش سرعت و دقت در پاسخدهی
-
مناسب برای مرور دورهای، تثبیت مطالب و جمعبندی پیش از آزمون
📍 توجه:
مبحث ۲۰۰۰ تست پلاس – عفونی فقط از طریق وبسایت رسمی MDThing قابل تهیه است و در حال حاضر نسخهی چاپی آن منتشر نمیشود.

نقد و بررسیها
هنوز بررسیای ثبت نشده است.